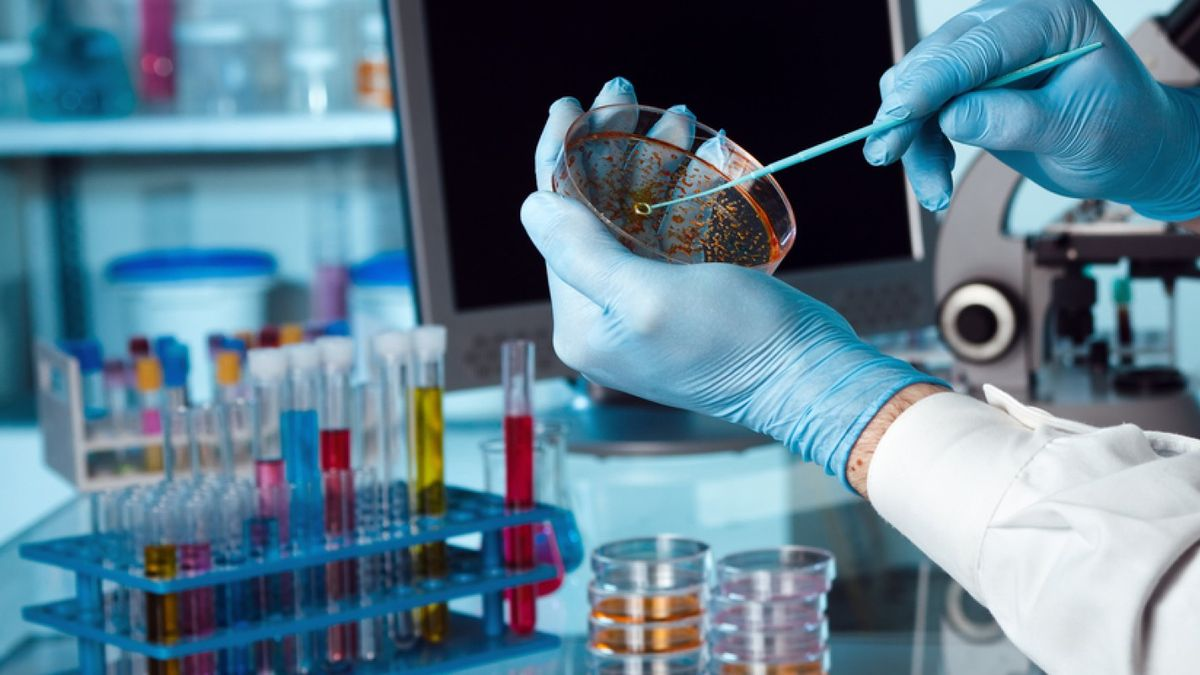

En un congreso celebrado el 15 de marzo de 2025 en Buenos Aires, empresarios y representantes de diversos sectores llamaron a construir una industria del Siglo XXI en Argentina. El evento reunió a funcionarios provinciales de diferentes alineaciones políticas, académicos y sindicalistas, quienes discutieron las oportunidades de desarrollo en múltiples sectores económicos. La reforma industrial fue un tema central, con un enfoque en la innovación y sostenibilidad como claves para el crecimiento a futuro. La convocatoria buscó unificar voces en torno a la necesidad de adaptar la industria local a los desafíos contemporáneos.
Desafíos y Oportunidades
Durante el congreso, se identificaron sectores específicos con oportunidades significativas. La industria tecnológica se destacó como un área con un potencial inmenso para generar empleo y mejorar la competitividad. Por su parte, la manufactura sostenible fue mencionada como una vía para no solo reducir la huella de carbono, sino también para atraer inversiones extranjeras. La agroindustria, por otro lado, tiene la capacidad de diversificar la oferta exportadora, siempre que se incorporen tecnologías y prácticas más eficientes.
Los empresarios enfatizaron que la educación y la capacitación laboral son fundamentales para aprovechar estas oportunidades. Se planteó la necesidad de alinear las currículas educativas con las demandas del mercado laboral actual y futuro. La colaboración entre empresas, universidades y el Estado se presenta como una estrategia esencial para crear un ecosistema que propicie la innovación. En este sentido, la formación continua se convierte en un pilar para que la fuerza laboral pueda adaptarse a las nuevas exigencias del sector industrial.
Un llamado a la acción conjunta
La participación activa de los funcionarios provinciales indicó un consenso sobre la importancia de trabajar en conjunto. Desde el ámbito gubernamental, se hizo un llamado para que las políticas públicas apoyen estos esfuerzos, estableciendo incentivos para la inversión y la investigación. Es vital crear un marco regulatorio que fomente la competitividad y la sostenibilidad, aprovechando la diversidad de ideas presentadas en el congreso. Esta unión entre el sector privado y el público es clave para materializar una visión industrial que no solo esté en sintonía con las tendencias globales, sino que también impulse el desarrollo local.
Finalmente, se resaltó que el cambio no será un proceso fácil, pero que la voluntad de transformación está presente. El diálogo entre los distintos actores de la economía puede ser la plataforma sobre la cual se construya un futuro más próspero y sostenible. Se invitó a todos los involucrados a mantener el compromiso y la colaboración más allá de este evento, buscando construir juntos la industria del Siglo XXI en Argentina. La mirada colectiva hacia un futuro innovador y responsable se vislumbra como la clave para el éxito en esta nueva etapa industrial.